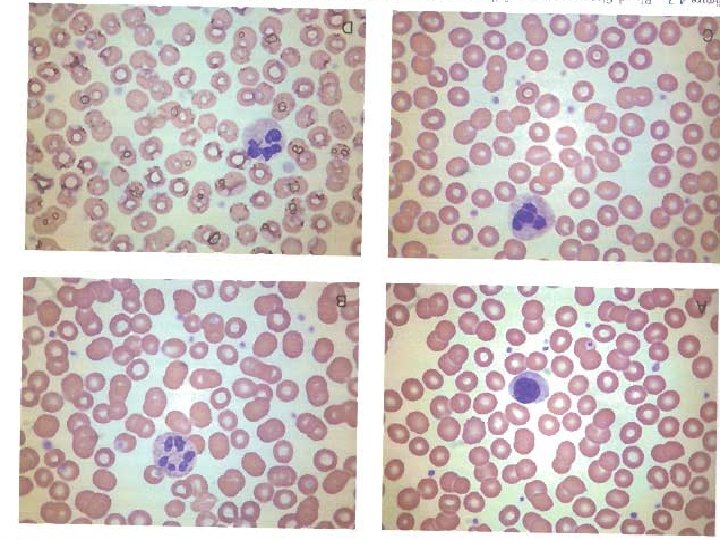

Staining of Blood Smear Romanowsky stain Romanowsky stainEosin

Staining of Blood Smear

Romanowsky stain • Romanowsky stain→Eosin Y and Azure B) Eosin: Acidic Dye bind to Basic groups (Hb, Granules) → reddish or orange color Azure B: Dye bind to nucleic acid & nucleoproteins →Blue-violet color Fixation →Methanol<4%water, with 1 hour Delay : Adherence of Pro. To slide → Blue background


Romanowsky stain • • • Wright – Giemsa Lishman May- grunwald - Giemsa jenner

Making blood film • Blood film can be prepared from fresh blood without anticoagulant or from EDTA anticoagulanted blood. • blood film should be made on clean glass. • Clear without any dust

Wedge method • The most commonly in routine lab • Method • Thickness or thinness regulated by • Amount of blood • Speed of spreader • Angle

Optimal blood smear characteristic • minimum 2. 5 cm in length terminating at least 1 cm from the end of the slide • Gradual Transition in thickness from thick to thin area ending in a Square or straight edge • No streaks , waves , or troughs

Sources of error in preparation of a blood smear problem Resolution Presence of crenated erythrocyte Dry smear quickly and thoroughly Thin smear due to anemia Increased spreader slide angle and increased push speed Thick smear due to polycythemia Decrease spreader slide angle and decrease push speed Presence of agglutinated erythrocytes associated with cold agglutinin disease Warm blood in 37°C for 15 min prior to preparing smear Increased viscosity associated with multiple myeloma Decrease spreader slide angle and decrease push speed

Spinner • Blood films that combine the advantages of easy handling of the wedge slide & uniform distribution of cells of the coverglass reparation • Method • Advantages: minimal exposure to biohazardous , increased optimal counting area

Reference method • Pure Azure B (260 mg/100 ml methanol) • Pure eosin y ( 130 mg/100 ml methanol) • 1 part Azure B + 1 part eosin y +10 part sorensens phosphate buffer 66 mmol/l ph= 6. 8 • 10 min • washing

Characteristic of aproperly stained blood smear Type of evaluation Characteristic Macroscopic Smear is pinkish purple in color Microscopic Blood cells are evenly distributed Areas between cells are clear Erythrocytes are orange red Neutrophilic granules are lilac Eosinophilic granules are red orange Lymphocytes cytoplasm is blue Leukocytes nuclei are purple Precipitated stain is minimal or absent

problem Potential causes Excessively blue or dark stain Prolonged staining Inadequate washing Too high an alkalinity of stain and / or buffer Thick blood smear Excessively pink or light stain Insufficient staining Prolonged washing Too high an acidity of stain and / or buffer Presence of precipitate Unclean slides Drying during staining process Inadequate filtration of stain

problem Potential causes Pale stainig Old stainig solution overused staining solution Impure dyes High ambient temperature Blue Background Prolonged storage before fixation Blood collection into heparinas anticoagulant



GOOD LUCK !
- Slides: 19